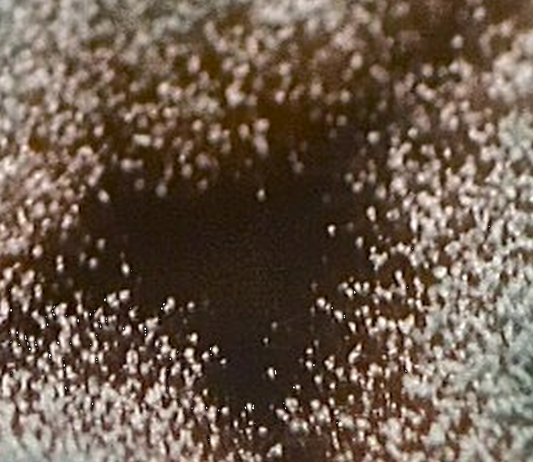
Mold is Starting to be a Regular Issue... Soooooo... What Do We Know About Mold?

This and That Blogs
Mold is Starting to be a Regular Issue... Soooo...
The thin threads that mold grow, contain bacteria, and contaminate whatever they touch, and can cause allergic symptoms and illness.
Mold is Starting to be a Regular Issue... Soooo...
The thin threads that mold grow, contain bacteria, and contaminate whatever they touch, and can cause allergic symptoms and illness.

Make Sure Your Home Does Not Have Toxins in the...
Test Your Home for Air Toxins With Monitors, and Detectors, for Your Guaranteed Healthy Air Quality.
Make Sure Your Home Does Not Have Toxins in the...
Test Your Home for Air Toxins With Monitors, and Detectors, for Your Guaranteed Healthy Air Quality.
